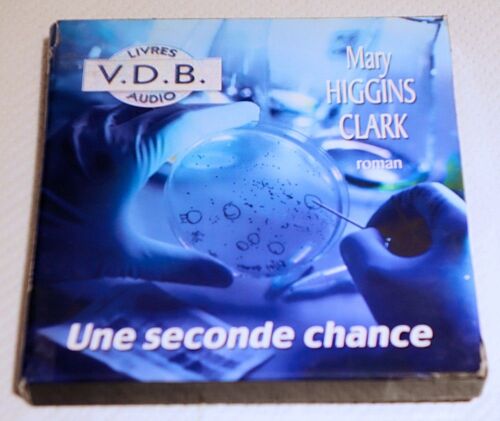
Une Seconde Chance

- Accueil
- Livres
- Autres catégories
- Higgins ed
Higgins Ed
35 résultats
Meilleures ventes
A propos de «Meilleures ventes»
- 01/06/2016
- Pack
- A partir de 12 ans
4 avis
Neuf dès 28,90 €
Occasion dès 7 €
Vendez le vôtre
- Format: Broché
Neuf à 18,64 €
Vendez le vôtre
- 26/09/2018
- Pack
- Tous public
Neuf dès 68,53 €
Occasion dès 14,89 €
Vendez le vôtre
- Avec Andrew Robinson / Blu-Ray 4K Horreur
- 26/02/2024
- Simple
- A partir de 10 ans
1 avis
Neuf dès 56,79 €
Vendez le vôtre
- 33 Tours
- Jazz
- 2022
Neuf dès 39,33 €
Occasion dès 60,99 €
Vendez le vôtre
Neuf dès 5,40 €
Occasion dès 5,18 €
Vendez le vôtre
- 21/10/2002
- Tous public
1 avis
Neuf dès 3,19 €
Occasion dès 0,90 €
Vendez le vôtre
- Format: Broché
Occasion dès 69,99 €
Vendez le vôtre
Vendez le vôtre
- Format: Non Precisé
Occasion dès 0,90 €
Vendez le vôtre
- Format: Broché
Occasion dès 1 €
Vendez le vôtre
1 avis
Occasion dès 4,05 €
Vendez le vôtre
Vendez le vôtre
- Collection: Succès du livre
- Format: Non Precisé
1 avis
Occasion dès 0,90 €
Vendez le vôtre
Vendez le vôtre
Vendez le vôtre
- Format: Non Precisé
Occasion dès 0,90 €
Vendez le vôtre
Vendez le vôtre
- Collection: Succès du livre
- Format: Non Precisé
1 avis
Occasion dès 0,90 €
Vendez le vôtre
- Format: Non Precisé
Occasion dès 0,90 €
Vendez le vôtre
- Format: Non Precisé
Occasion dès 6,49 €
Vendez le vôtre
Vendez le vôtre
- Format: Non Precisé
Occasion dès 1,50 €
Vendez le vôtre
- Collection: Succès Du Livre Collection
- Format: Non Precisé
1 avis
Occasion dès 0,90 €
Vendez le vôtre
- Collection: Succès du livre
- Format: Non Precisé
1 avis
Occasion dès 0,90 €
Vendez le vôtre
- Collection: Succès du livre
- Format: Non Precisé
1 avis
Occasion dès 0,90 €
Vendez le vôtre
- Format: Non Precisé
Occasion dès 0,90 €
Vendez le vôtre
- Collection: Le livre de poche
- Format: Poche
4 avis
Occasion dès 0,90 €
Vendez le vôtre
Occasion dès 16,97 €
Vendez le vôtre
- Format: Broché
Occasion dès 27,95 €
Vendez le vôtre
- 1



![Hellraiser: Tetralogy (Special Edition) [Ultra Hd] Boxed Set, Special Ed, Uk - Import](https://fr.shopping.rakuten.com/pictures/0198bda1-bdea-72ea-a0cc-f856cfd608b7_L_NOPAD.jpg)
![Billy Higgins - The Soldier [Vinyl Lp] Colored Vinyl, Green, Ltd Ed, 180 Gram](https://fr.shopping.rakuten.com/pictures/019992b1-ed41-7e77-b8d4-1b8faea54da4_L_NOPAD.jpg)